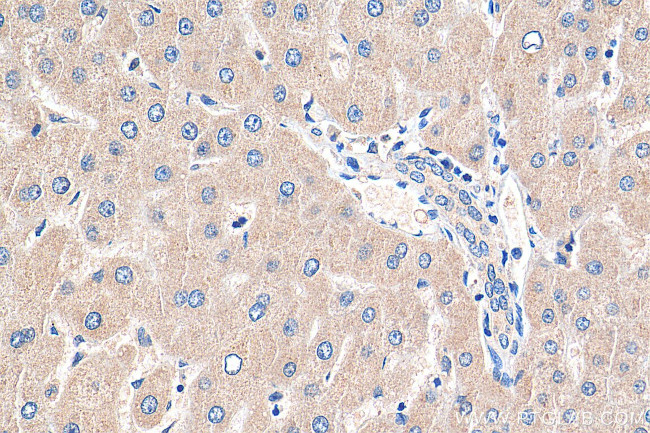
MYEOV Antibody in Immunohistochemistry (Paraffin) (IHC (P))

Search
Proteintech
MYEOV Polyclonal Antibody
{{$productOrderCtrl.translations['antibody.pdp.commerceCard.promotion.promotions']}}
{{$productOrderCtrl.translations['antibody.pdp.commerceCard.promotion.viewpromo']}}
{{$productOrderCtrl.translations['antibody.pdp.commerceCard.promotion.promocode']}}: {{promo.promoCode}} {{promo.promoTitle}} {{promo.promoDescription}}. {{$productOrderCtrl.translations['antibody.pdp.commerceCard.promotion.learnmore']}}
产品信息
11151-1-AP
种属反应
已发表种属
宿主/亚型
分类
类型
抗原
偶联物
形式
浓度
规格
纯化类型
保存液
内含物
保存条件
运输条件
产品详细信息
Immunogen sequence: MALRICVTY TPALPIGLCT RCCLCLEQSP SWCHCLRGVS FLTFHLHQSV PLGDRDSLLM FTRQAGHFVE GSKAGRSRGR LCLSQALRVA VRGAFVSLWF AAGAGDRERN KGDKGAQTGA GLSQEAEDVD VSRARRVTDA PQGTLCGTGN RNSGSQSARA VGVAHLGEAF RVGVEQAISS CPEEVHGRHG LSMEIMWARM DVALRSPGRG LLAGAGALCV TLAESSCPDY ERGRRACLTL HRHPTPHCST WGLPLRVAGS WLTVVTVEAL GGWRMGVRRT GQVGPTMHPP PVSGASPLLL HHLLLLLLII ILTC (1-313 aa encoded by BC011815)
靶标信息
MYEOV, also named as OCIM, was originally isolated by the application of the NIH/3T3 tumorigenicity assay with DNA from a gastric carcinoma. It is a prognostic factor for patients with multiple myeloma, in part through a role of MYEOV in the control of MMC proliferation. MYEOV is a candidate oncogene activated in the amplification core located proximal toCCND1.
仅用于科研。不用于诊断过程。未经明确授权不得转售。
生物信息学
蛋白别名: myeloma overexpressed (in a subset of t(11;14) positive multiple myelomas); myeloma overexpressed gene (in a subset of t(11;14) positive multiple myelomas); Myeloma-overexpressed gene protein; OCIM; Oncogene in multiple myeloma; unnamed protein product
基因别名: MYEOV; OCIM
UniProt ID: (Human) Q96EZ4
Entrez Gene ID: (Human) 26579